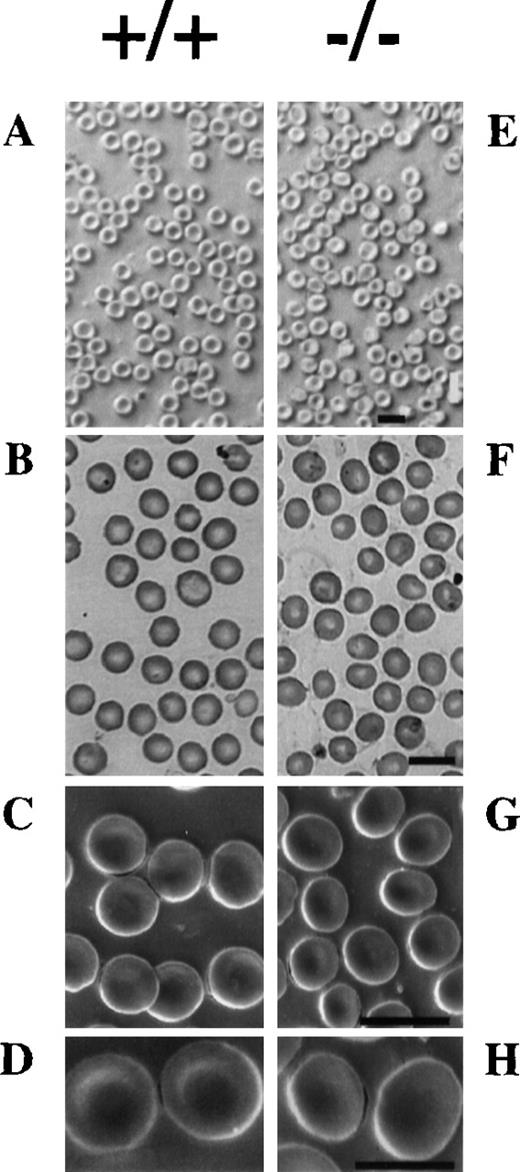
Fig. 4. Morphology of RBCs. / Native (A and E) and May-Gruenwald Giemsa stained (B and F) light microscopy and scanning electron (C, D, G, and H) microscopy of peripheral blood smears of wild-type (A, B, and C) and mutant (D, E, and F) mice. The abnormal morphology and the decrease in the concavity of erythrocytes of mutant mice is seen. Bar 10 μm (A, B, C, E, F, and G), 5 μm (D and H).

Abstract
The membrane skeleton, a dynamic network of proteins associated with the plasma membrane, determines the shape and mechanical properties of erythrocytes. Deficiencies or defects in membrane skeletal proteins are associated with inherited disorders of erythrocyte morphology and function. Adducin is one of the proteins localized at the spectrin-actin junction of the membrane skeleton. In this work we show that deficiency of β-adducin produces an 80% decrease of -adducin and a fourfold up-regulation of γ-adducin in erythrocytes. β-Adducin or any other isoform generated by translation of abnormally spliced messenger RNAs could not be detected by our antibodies either in ghosts or in cytoplasm of −/− erythrocytes. Actin levels were diminished in mutant mice, suggesting alterations in the actin-spectrin junctional complexes due to the absence of adducin. Elliptocytes, ovalocytes, and occasionally spherocytes were found in the blood film of −/− mice. Hematological values showed an increase in reticulocyte counts and mean corpuscular hemoglobin concentration, decreased mean corpuscular volume and hematocrit, and normal erythrocyte counts that, associated to splenomegaly, indicate that the mice suffer from mild anemia with compensated hemolysis. These modifications are due to a loss of membrane surface and dehydration that result in an increase in the osmotic fragility of red blood cells. The marked alteration in osmotic fragility together with the predominant presence of elliptocytes is reminiscent of the human disorder called spherocytic hereditary elliptocytosis. Our results suggest that the amount of adducin remaining in the mutant animals (presumably γ adducin) could be functional and might account for the mild phenotype.
The erythrocyte membrane skeleton, a dynamic network of proteins associated with the plasma membrane, determines the shape and mechanical properties of the red blood cells (RBCs). Spectrin, the most abundant component of this two-dimensional lattice, is organized into a polygonal network linked to short actin filaments. The spectrin-actin junctions contain a group of proteins that promote and modulate spectrin-actin interactions, form membrane associations, and regulate the actin filament length.1
Erythrocyte adducin is one of the proteins localized at the spectrin-actin junction. The adducin protein family is composed of 3 members encoded by closely related genes: α-, β-, and γ-adducin.2,3 Both α- and β-adducin primary transcripts undergo alternative splicing, generating a wide variety of messenger RNAs (mRNAs),4-8 although there is no evidence that all generated isoforms are translated to proteins. The α and β subunits, but not the γ, are found in human erythrocytes as a mixture of heterodimers and heterotetramers, whereas combinations of α/β and α/γ oligomers are found in other cells.3,9 Adducin subunits have 3 distinct domains: a 39 kd NH2-terminal globular protease-resistant head domain, a 9 kd neck domain, and a protease-sensitive tail domain.10 They are phosphorylated by protein kinases A (PKA) and C (PKC).11-13 α-Adducin is also phosphorylated by tyrosine kinase and Rho-kinase.13,14The COOH termini of adducin monomers contain a basic stretch of 22 amino acids highly homologous to MARCKS proteins3,10 that bind to calmodulin and contain the major PKC phosphorylation sites.12 The MARCKS domain, together with a recently described oligomerization domain localized in the neck region, is required to form a complex with the fast-growing ends of actin filaments recruiting spectrin and preventing addition or loss of actin subunits.15 Contrary to the tail and neck domains, in vitro experiments with recombinant mutated β-adducin showed that the head domain is not necessary for spectrin-actin interactions, but it could be important for tetramer formation.11
Erythrocyte adducin binds to the spectrin-actin complex promoting the assembly of additional spectrin molecules onto actin filaments,16 bundles actin filaments,17 and acts as capping protein of the barbed (fast growing) ends of actin filaments.18 These functions are regulated by phosphorylation and Ca++-calmodulin interactions.9,12,17,19,20 In nonerythroid cells, it has been shown that hts, a Drosophila adducin-related protein, co-localizes with spectrin, and it is required for ring canal formation (an actin-rich structure) during oogenesis.21,22 In mammals, adducin is found at sites of cell-to-cell contact in a Ca++-dependent localization, promoting the assembly of spectrin (or fodrin) into a more stable structure.19
Our group identified α- and β-adducins as proteins carrying mutations in the Milan hypertensive rat strain.4Interestingly, the Milan hypertensive rat strain erythrocytes were smaller and osmotically more fragile than those of the Milan normotensive rat strain.23 To elucidate the in vivo role of β-adducin, we have used gene targeting in embryonic stem (ES) cells to create a null mutation in mice. In this work, we analyzed the hematological consequences of the deficiency of β-adducin. The absence of β-adducin resulted in an 80% reduction in the α-adducin and 15% in actin levels, and in the fourfold up-regulation of the γ-adducin subunit. We found that β-adducin-mutant mice developed a mild compensated hemolytic anemia characterized by increased osmotic fragility (OF) and elliptocytosis.
Materials and methods
Targeted disruption of the β-adducin gene
An 18.5-kilobase (kb) genomic clone for the murine β-adducin gene extending from intron 5 to intron 15 was isolated from a 129/Sv lambda FixII library (a gift of G. Friedrich). The 8.0-kb BamHI fragment (containing exons 6 to 8) and the 2-kb EcoRI-XbaI fragment (having exon 14) were cloned into the HindIII and BamHI sites of the pD350.1 vector (carrying the neomycin phosphotransferase [NeoR] cassette), respectively. The complete insert was cloned into a pBSKSII vector already containing the thymidine kinase gene. Transfected MPI II ES cells24 were cultured and selected with G418 and gancyclovir. Genomic DNA of selected clones was analyzed by Southern blot, using an 800 base pair (bp) 3′ external probe fragment (Figure 1A). Morula aggregation and embryo transfer were performed using standard techniques. Male chimeras, identified by coat color, were mated to C57BL/6 females to generate heterozygous animals. They were crossed with C57BL/6 animals for 5 generations to obtain a homogeneous C57BL/6 inbred background, arriving to 98.4% of C57 BL/6 genetic background. For Southern blot analysis, tail DNA was digested either with XbaI or with EcoRI and hybridized with an internal or external probe, respectively.
Comparison of mouse, rat, and human amino acid sequences.
Alignment of amino acid sequences of mouse, rat, and human β-adducin (β-Add97 form). The putative Δ9-13 β-adducin gene product generated from β-adducin −/− mice is indicated as “mouse −/−.” Filled triangles and numbering indicate the represented exons according to Gilligan et al.7 White triangles in exons 10 and 11 indicate the end of the β-adducin head domain (aa 1-338) and the beginning of the tail region (aa 419-726), respectively. The neck region (aa 339-418) is located in between the white triangles. The boxes indicate the different functional domains: oligomerization domain (aa 335-436, 99% identity),15calmodulin-binding domain (aa 425-461, 97.2% identity),27PKA phosphorylation region (aa 523-534, 100% identity),13and calmodulin-binding domain (MARCKS domain, aa 705-721, 100% identity).2 12 Asterisks indicate identical residues, whereas 2 dots indicate conservative substitutions. Aa sequences have an overall 90.0% identity and 94.8% similarity.
Comparison of mouse, rat, and human amino acid sequences.
Alignment of amino acid sequences of mouse, rat, and human β-adducin (β-Add97 form). The putative Δ9-13 β-adducin gene product generated from β-adducin −/− mice is indicated as “mouse −/−.” Filled triangles and numbering indicate the represented exons according to Gilligan et al.7 White triangles in exons 10 and 11 indicate the end of the β-adducin head domain (aa 1-338) and the beginning of the tail region (aa 419-726), respectively. The neck region (aa 339-418) is located in between the white triangles. The boxes indicate the different functional domains: oligomerization domain (aa 335-436, 99% identity),15calmodulin-binding domain (aa 425-461, 97.2% identity),27PKA phosphorylation region (aa 523-534, 100% identity),13and calmodulin-binding domain (MARCKS domain, aa 705-721, 100% identity).2 12 Asterisks indicate identical residues, whereas 2 dots indicate conservative substitutions. Aa sequences have an overall 90.0% identity and 94.8% similarity.
Detection of gene products
Total RNA was isolated from brain and spleen from wild-type (+/+), heterozygous (+/−), and mutant (−/−) mice and loaded in 1.2% agarose-formaldehyde gels (20 μg/lane), transferred to nylon membranes, and hybridized with an entire rat β-adducin complementary DNA (cDNA) probe.4
cDNA cloning of wild type and deleted β-adducins
The cDNA from 1 μg of spleen total RNA from +/+ and −/− mice was generated using a standard reverse transcription protocol. The cDNA was PCR-amplified with primers based on the β-Add97 rat sequence (5′ CTCTCAGGGGCAGCACTACTTTG 3′ and 5′ AGGACCCACTGAGCCACTAATCAG 3′, respectively). The PCR products were cloned and fully sequenced (GeneBank Accession Numbers: AF189 769 and AF189 770 for wild-type- and Δ9-13-β-Adducins, respectively). At least 3 clones originated from independent RT-PCR reactions were sequenced and compared to detect possible mutations introduced by the RT-PCR procedure.
Light and scanning electron microscopy
Blood smears were air dried and viewed under a light microscope either without staining by use of simple contrast enhancement obtained by closure of iris and slight decentering of the condensator or with staining by May-Gruenwald Giemsa and viewed in conventional bright field. Scanning electron microscopy of RBCs was performed on the native blood smears from peripheral blood with the use of the Variable Pressure Scanning Electron Microscope SEM LEO 435VP or sputter coated by gold and examined by JEOL JSM 5800 scanning electron microscope.
Protein analysis of RBCs
Erythrocyte ghosts were prepared from freshly drawn blood anticoagulated in EDTA as described by Bennett25 with minor modifications. Ghost membranes were extracted with a Triton X-100 containing solution (10 mmol/L Tris HCl, pH = 8.2; 100 mmol/L NaCl; 1 mmol/L EDTA; 2 mmol/L DTT; 0.5% Triton X-100; and protease inhibitors). After centrifugation (18 000g for 40 minutes), the pellets (cytoskeletons) were resuspended and re-extracted in the same solution. Finally, they were washed twice with the same buffer without Triton. For cytoplasm protein preparations, RBCs were separated, washed, and lysed in 7.5 mmol/L sodium phosphate (pH = 7.5), 1 mmol/L EDTA, and protease inhibitors as described25 with minor modifications. The lysed RBCs were ultracentrifuged, and the supernatant was used for further analysis. The protein concentrations were measured by triplicate with the Bio-Rad Protein Assay Kit. Membrane and cytoskeletal proteins were electrophoresed on a 5%-17% (Laemmli system) gradient SDS-PAGE. The gels were stained with Coomassie blue and analyzed by densitometry, using the NIH Image 1.61 software.
For Western blot, cytoplasmatic and ghost proteins were electrophoresed on an 8% Laemmli gel, blotted onto nitrocellulose membranes, and probed with the rabbit anti-α-, β-, and γ-adducin polyclonal antibodies (1:500, 1:1000, and 1:1000 dilution, respectively). The experiments were repeated with identical results with 3 independent protein preparations.
Antibodies
Anti-α- and β-adducin polyclonal antibodies were generated by immunizing rabbits with recombinant full-length rat α- and β-Add97 adducin subunits, respectively. Anti-mouse Δ9-13 β-adducin antibodies were generated by expressing the full-length deleted cDNA (that was cloned from −/− mice, see above) in a bacteria system, and the SDS-PAGE purified protein was used as immunogen. Anti-γ-adducin antibodies were obtained by immunizing rabbits with the recombinant C-terminal region of the mouse γ-subunit (GeneBank Accession Number: AF189 772). The antibodies showed no cross-reactivity in the conditions used in the experiments.
Hematological analysis
Blood from 4- to 5-month-old wild-type and β-adducin −/− mice was collected in EDTA-containing tubes. Routine hematologic parameters were determined on a Technicon H-1 cell counter, using veterinary software containing mouse parameters. Reticulocyte counts were performed using the Reti-Count kit (Becton Dickinson) in a FACS analyser (FACSCalibur, Becton Dickinson) and confirmed using the standard methylene blue coloration of the same samples. Total bilirubin levels were analyzed according to standard methods.
Osmotic fragility test
This test was performed from freshly drawn blood as indicated by Try,26 except that the NaCl solutions used were [% (wt/vol)] 0.300, 0.350, 0.400, 0.450, 0.475, 0.500, 0.525, 0.550, 0.575, 0.600, 0.625, and 0.650. Five 2- to 4-month-old and 5 8- to 10-month-old wild-type and −/− mice were analyzed. The experiment was repeated 3 times with similar results.
Results
Targeted disruption of the β-adducin gene
The human β-adducin gene consists of 17 exons that span more than at least 100 kb.7 Its primary transcript undergoes a complex pattern of alternative splicing,6-8 generating the β-Add97 and β-Add63 mRNAs families.4 The β-Add97 form (also called β1 form7) contains all exons, except for a novel 86 bp exon8 and is the most abundant form.2 The β-Add63 form, also called β2,7is generated on utilization of a polyadenylation site found in the unspliced intron that follows exon 13.4,6 Exons 9, 11, and 12 can function as acceptor splicing sites for alternatively spliced mRNAs both from the β-Add97 and β-Add63 mRNA families previously described.4 6-8 However, all possible β-adducin isoforms have not yet been detected.
We have cloned and sequenced the mouse β-Add97 cDNA (GeneBank Accession Number: AF189 769), and sequence comparison between human, rat, and mouse β-adducin mRNAs showed 86.3% homology between them and 95.8% between rat and mouse cDNAs. Comparison of the amino acid sequences showed 90.2% identity and 96.0% similarity between human, rat, and mouse β-adducin subunits (Figure 1). The identity was almost complete for the functional domains, suggesting a total conservation of adducin functions across species (Figure 1).
To analyze the in vivo function of β-adducin, we carried out a targeted disruption of the β-adducin gene. We cloned an 18.5-kb genomic fragment containing exons 6 to 15 from a c129/Sv mouse library. Then, we deleted exons 9 to 13 and replaced them with a NeoR cassette in our targeting construct. This deletion ensured the elimination of all β-adducin mRNA isoforms6,7 (Figures 1 and2A) and the exons that encompass the most important functional domains, including the newly defined oligomerization domain,15 the calmodulin-binding domain of the neck region,27 PKA phosphorylation sites,13the region containing the R529Q polymorphism associated with hypertension in rats,13 and a major part of the tail domain responsible for modulating adducin activity15,17,18 20(Figure 1). The deletion of exons 9 to 13 should then result in the elimination of β-adducin known functions.
Targeted disruption of the mouse β-adducin gene.
(A) Partial restriction map of a portion of the mouse β-adducin locus with the targeting construct and the resulting targeted allele shown below. Numbered boxes represent exons according to the numbering in humans.7 Asterisks indicate exons containing acceptor splicing sites used in β-adducin alternative splicing. The β-Add63 isoform is generated by unprocessing of the intron located downstream of exon 13.4 The NeoR cassette (NEO) and the thymidine kinase gene (TK) are marked. EcoRI (R) and EcoRV (V) restriction sites are indicated. An 800-bp 3′ flanking fragment (black bar over exon 17) was used as the Southern blot hybridization probe. The expected bands for EcoRI and EcoRV cuts are indicated. (B) DNA of G418 resistant clones was cut with EcoRI (lanes 1-4) or EcoRV (lanes 5-8) and analyzed by Southern blot. Homologous recombination occurred in 2 clones (lanes 1 and 3; and 5 and 7) as indicated by the presence of both wild-type and targeted alleles.
Targeted disruption of the mouse β-adducin gene.
(A) Partial restriction map of a portion of the mouse β-adducin locus with the targeting construct and the resulting targeted allele shown below. Numbered boxes represent exons according to the numbering in humans.7 Asterisks indicate exons containing acceptor splicing sites used in β-adducin alternative splicing. The β-Add63 isoform is generated by unprocessing of the intron located downstream of exon 13.4 The NeoR cassette (NEO) and the thymidine kinase gene (TK) are marked. EcoRI (R) and EcoRV (V) restriction sites are indicated. An 800-bp 3′ flanking fragment (black bar over exon 17) was used as the Southern blot hybridization probe. The expected bands for EcoRI and EcoRV cuts are indicated. (B) DNA of G418 resistant clones was cut with EcoRI (lanes 1-4) or EcoRV (lanes 5-8) and analyzed by Southern blot. Homologous recombination occurred in 2 clones (lanes 1 and 3; and 5 and 7) as indicated by the presence of both wild-type and targeted alleles.
After ES cell electroporation and selection, we obtained 2 positive clones from 350 G418 resistant clones (Figure 2B). Chimeras were obtained by morula aggregation, and germ-line transmission of the targeted allele was confirmed by Southern blot of agouti progeny. Mice heterozygous for the β-adducin mutation were fertile and showed no obvious phenotypical alterations. The heterozygous animals were crossed for 5 generations to obtain a homogeneous C57BL/6 background. After intercrosses of heterozygous animals, we obtained homozygous mice. The targeted allele segregated at the expected mendelian frequency, revealing 26.2% of β-adducin mutant mice, 47.6% of heterozygous mice, and 26.2% of wild-type mice from 126 offspring born from 19 heterozygous +/− mating pairs. β-Adducin −/− mice reached adulthood without showing any obvious phenotypical abnormality, and they reproduced at the same rate as their wild-type littermates. Also, no difference by gross histological and pathological analysis of mouse organs from −/− mice was detected, except for the observed splenomegaly described below.
RNA and protein analysis of β-adducin in mutant mice
Northern blot analysis showed the presence of smaller mRNA species both in total RNA from brain and spleen of −/− animals (Figure3A). Deletion of exons 9 to 13 corresponded to a reduction of 744 bases of the β-Add97 mRNA and the elimination of all the 3′ coding and noncoding end of β-Add63. The β-adducin major transcript observed in −/− brain was clearly smaller than the 8-kb mRNA found in the wild-type brain, and its size (approximately 7.3 kb) corresponded to the deleted β-adducin mRNA lacking the 744 bases (compare bands a- and b-, Figure 3A). A similar size reduction in brain transcripts of −/− mice was seen for the minor β-adducin expressed mRNAs in the 3-kb to 4-kb region (Figure3A, region c-). The 2 mRNA species observed in −/− spleen (Figure3A, bands e- and f-) were also smaller than the Add97 mRNAs seen in wild-type animals (Figure 3A, band d-). Cloning and sequencing of band e- mRNA confirmed the absence of exons 9 to 13 (Figure 1) from the mutant mRNA (GeneBank Accession Number: AF189769). We have not investigated the nature of band f-. The heterozygous animals presented both the wild-type and deleted mRNA forms in brain and spleen. Very low levels of the 7.3-kb transcript were seen in the brain of the −/− mice (21% of the level of the 8-kb transcript in wild-type animals, Figure 3A and C), and a minor decrease in mRNA levels was detected in the heterozygous brain (83% of the wild type, Figure 3A and C). On the contrary, no differences in mRNA levels between wild-type and mutant animals were observed in the spleen (Figure 3A and C).
RNA and protein analysis of the β-adducin −/− mice.
(A) Northern blot analysis of brain and spleen β-adducin mRNA from adult wild-type (+/+), heterozygous (+/−), and homozygous mutant (−/−) mice. The arrows indicate the different β-adducin mRNA species detected. (B) Methylene blue staining of the membrane utilized in A. (C) The signals obtained in A were normalized against the 18S RNA content present in the membrane. RNA levels are expressed as a percentage of the RNAs of wild-type mice for each tissue. (D) Western blot analysis of brain (lanes 1-6) and spleen (lanes 7-9) protein extracts (30 μg) from adult wild-type (+/+), heterozygous (+/−), and homozygous mutant (−/−) mice using a rabbit anti-mouse β-adducin Δ9-13 polyclonal antibody. Lanes 4-6 are a 15× overexposure of the blot shown in lanes 1-3. The β-adducin (β-Add97 form) bands are marked by black arrows. (E) Western blot analysis of ghost proteins (lanes 1-3, 0.7 μg; lane 4, 10 μg), bacteria purified recombinant mouse β-adducin Δ9-13 (lanes 8 and 9, containing 2 and 5 ng of purified protein, respectively), and RBC cytoplasmic proteins (lanes 10-12, 100 μg) was revealed with the same antibody utilized in panel D. Lanes 1 to 3 are a lower exposure of the blot shown in lanes 5 to 7. The β-adducin (β-Add97 form) and the recombinant β-adducin Δ9-13 product (Rec.) are marked by a black arrow and a black dot, respectively. The lower molecular weight bands seen in lane 10 are marked by gray arrows.
RNA and protein analysis of the β-adducin −/− mice.
(A) Northern blot analysis of brain and spleen β-adducin mRNA from adult wild-type (+/+), heterozygous (+/−), and homozygous mutant (−/−) mice. The arrows indicate the different β-adducin mRNA species detected. (B) Methylene blue staining of the membrane utilized in A. (C) The signals obtained in A were normalized against the 18S RNA content present in the membrane. RNA levels are expressed as a percentage of the RNAs of wild-type mice for each tissue. (D) Western blot analysis of brain (lanes 1-6) and spleen (lanes 7-9) protein extracts (30 μg) from adult wild-type (+/+), heterozygous (+/−), and homozygous mutant (−/−) mice using a rabbit anti-mouse β-adducin Δ9-13 polyclonal antibody. Lanes 4-6 are a 15× overexposure of the blot shown in lanes 1-3. The β-adducin (β-Add97 form) bands are marked by black arrows. (E) Western blot analysis of ghost proteins (lanes 1-3, 0.7 μg; lane 4, 10 μg), bacteria purified recombinant mouse β-adducin Δ9-13 (lanes 8 and 9, containing 2 and 5 ng of purified protein, respectively), and RBC cytoplasmic proteins (lanes 10-12, 100 μg) was revealed with the same antibody utilized in panel D. Lanes 1 to 3 are a lower exposure of the blot shown in lanes 5 to 7. The β-adducin (β-Add97 form) and the recombinant β-adducin Δ9-13 product (Rec.) are marked by a black arrow and a black dot, respectively. The lower molecular weight bands seen in lane 10 are marked by gray arrows.
Although a deleted mRNA form was present in the brain and spleen of mutant mice, no protein (normal or deleted forms) was detected either in these tissues or in RBC skeletons of β-adducin −/− mice by Western blot, using polyclonal antibodies against the deleted form produced by translation of the cloned cDNA lacking exons 9 to 13 (Figure 3D and 3E), or against the full-length rat β-adducin. This finding was also observed in other tissues of mutant mice (data not shown). The anti-mouse Δ9-13 β-adducin antibody recognized efficiently the wild-type β-adducin subunit in brain, spleen, and RBC ghosts (Figure 3D, lanes 1, 4, and 7; Figure3E, lane 1 and 5). The absence of β-adducin or any deleted product was observed in −/− animals (Figure 3D, lanes 3 and 9; Figure 3E, lane 3). This finding was further confirmed in a much higher exposure of these lanes (Figure 3D, lane 6 and Figure 3E, lane 7) and by the absence of signal in an overloaded well of −/− ghost sample (15 times the amount loaded before; Figure 3E, lane 4). Brain and spleen from +/− animals had approximately 50% of β-adducin levels found in +/+ mice (Figure 3D, lanes 2, 5, and 8). However, only a 15% reduction of the β-adducin levels (± 6%, n = 3) was observed in β-adducin levels of ghosts prepared from heterozygous +/− mice (Figure 3E, lanes 2 and 6). Protein extracts of RBC cytoplasm showed the absence of β-adducin in wild-type, heterozygous, or homozygous mutant mice (Figure 3E, lanes 10-12). However, 2 specific minor bands of lower molecular weight were seen in the wild-type sample that might be degradation products of the full-length β-adducin not incorporated into the membrane skeleton of the RBCs (Figure 3E, lane 10, gray arrows). Furthermore, we were unable to detect the presence of any deleted isoform in the cytoplasmic protein extracts from +/− and −/− mice (Figure 3E, lanes 11-12), suggesting that putative translational products of the targeted allele, if present, might be degraded in the RBC cytoplasm of these mice.
Hematological analysis of β-adducin −/− mice
Hematological analysis showed evidence of mild anemia with compensated hemolysis in the β-adducin −/− mice. There was a significant decrease in the hematocrit, mean corpuscular hemoglobin (MCH), and hemoglobin values in these mice (Table1); erythrocytes were significantly smaller and had a significant increase in mean corpuscular hemoglobin concentration (MCHC) values, suggesting a loss of membrane surface and dehydration. Reticulocyte counts were increased in +/− and −/− mice, having the +/− animals an intermediate value between +/+ and −/− mice. Spleen weight ranged from 0.3% in control mice to 1% of the animal weight in −/− mice. These data indicate hemolysis of mutant RBCs that are consistent with the observed splenomegaly. Finally, bilirubin analysis showed slightly higher levels in mutant mice. These data suggested the presence of a mild anemia with compensated hemolysis in mutant mice.
Hematological parameters of wild-type and β-adducin −/− mice
| Genotype . | +/+ . | +/−* . | −/−† . |
|---|---|---|---|
| n | 11 | 8 | 9 |
| RBC (106/μL) | 9.62 ± 0.08 | 9.71 ± 0.24 | 9.49 ± 0.27 |
| MCH (pg)‡ | 14.75 ± 0.08 | 14.81 ± 0.06‡ | 14.39 ± 0.111-153 |
| MCHC (g/dL)‡ | 30.92 ± 0.16 | 30.74 ± 0.14‡ | 31.40 ± 0.071-153 |
| MCV (fl)1-154 | 47.71 ± 0.25 | 48.20 ± 0.251-154 | 45.83 ± 0.351-154 |
| Hematocrit (%)1-153 | 46.10 ± 0.50 | 46.80 ± 1.201-153 | 43.50 ± 0.601-155 |
| Hemoglobin (g/dL) | 14.25 ± 0.13 | 14.35 ± 0.36 | 13.63 ± 0.191-153 |
| Reticulocytes (%)1-154 | 4.58 ± 0.19 | 5.49 ± 0.24‡,1-155 | 6.76 ± 0.251-154 |
| Genotype . | +/+ . | +/−* . | −/−† . |
|---|---|---|---|
| n | 11 | 8 | 9 |
| RBC (106/μL) | 9.62 ± 0.08 | 9.71 ± 0.24 | 9.49 ± 0.27 |
| MCH (pg)‡ | 14.75 ± 0.08 | 14.81 ± 0.06‡ | 14.39 ± 0.111-153 |
| MCHC (g/dL)‡ | 30.92 ± 0.16 | 30.74 ± 0.14‡ | 31.40 ± 0.071-153 |
| MCV (fl)1-154 | 47.71 ± 0.25 | 48.20 ± 0.251-154 | 45.83 ± 0.351-154 |
| Hematocrit (%)1-153 | 46.10 ± 0.50 | 46.80 ± 1.201-153 | 43.50 ± 0.601-155 |
| Hemoglobin (g/dL) | 14.25 ± 0.13 | 14.35 ± 0.36 | 13.63 ± 0.191-153 |
| Reticulocytes (%)1-154 | 4.58 ± 0.19 | 5.49 ± 0.24‡,1-155 | 6.76 ± 0.251-154 |
All values are X ± SEM. RBC indicates red blood cell; MCHC, main corpuscular hemoglobin concentration; MCV, main corpuscular volume; +/+, +/−, and −/− indicate normal littermate controls, heterozygous, and β-adducin mutant animals, respectively. Statistical analysis was done using the unpaired ANOVA test with the BMDP software.
The P values indicated were obtained when +/− mice were compared with −/− animals, except for the reticulocyte counts were two P values were obtained: P ≤ .01 when +/+ were compared with +/− animals, and P ≤ .005 when +/− were compared with −/− mice.
The P values were obtained when −/− mice were compared with +/+ mice.
P ≤ .01.
P ≤ .05.
P ≤ .005.
P ≤ .0005.
Light and scanning electron microscopy of RBCs
Light and scanning electron microscopy of peripheral blood smears of β-adducin −/− mice showed heterogeneity of the erythrocyte shapes, including normal erythrocytes, elliptocytes, rounded elliptocytes, and occasional spherocytes (Figure4). Extreme elliptocytosis in the form of rod-shaped elliptocytes was not found. The RBCs from mutant mice had the degree of concavity much less pronounced than normal, indicating that the cells are thicker.
Morphology of RBCs.
Native (A and E) and May-Gruenwald Giemsa stained (B and F) light microscopy and scanning electron (C, D, G, and H) microscopy of peripheral blood smears of wild-type (A, B, and C) and mutant (D, E, and F) mice. The abnormal morphology and the decrease in the concavity of erythrocytes of mutant mice is seen. Bar 10 μm (A, B, C, E, F, and G), 5 μm (D and H).
Morphology of RBCs.
Native (A and E) and May-Gruenwald Giemsa stained (B and F) light microscopy and scanning electron (C, D, G, and H) microscopy of peripheral blood smears of wild-type (A, B, and C) and mutant (D, E, and F) mice. The abnormal morphology and the decrease in the concavity of erythrocytes of mutant mice is seen. Bar 10 μm (A, B, C, E, F, and G), 5 μm (D and H).
OF analysis of RBCs
The OF test is the most sensitive test generally available to detect cells that are less tolerant to osmotic stress than normal cells.28 The RBCs from β-adducin −/− mice showed an increase in their in vitro OF when exposed to hypotonic NaCl solutions. We found that the NaCl concentration that produced 50% hemolysis (C50) was sharply higher in the mutant mice (Figure5), whereas heterozygous +/− animals showed an intermediate OF phenotype. C50 values were 0.585% [wt/vol] NaCl for −/− RBCs, and 0.545% and 0.501% NaCl for +/− and +/+ mice, respectively (Table2). Younger (2- to 4-month-old) +/+ and −/− animals had similar C50 values as the 8- to 10-month-old mice but the +/− curve was similar to that of controls. The C50 values for the younger mice were 0.569%, 0.510%, and 0.517% for −/−, +/−, and +/+ mice, respectively. The values of the β parameter, an estimation of the sharpness of the cellular distribution,26 were lower in mutant mice, indicating that their RBC distribution was more heterogeneous (not shown).
Osmotic fragility test of RBCs.
Erythrocytes from +/+ (⋄), +/− (□), and −/− (▵) mice were subjected to an OF test as described in the “Materials and methods” section. Results (mean ± standard error of 5 8- to 10-month-old animals/group) are expressed as percentage of lysis in graded salt concentrations. C50 values were determined by logarithmic linearization of the OF curve.26
Osmotic fragility test of RBCs.
Erythrocytes from +/+ (⋄), +/− (□), and −/− (▵) mice were subjected to an OF test as described in the “Materials and methods” section. Results (mean ± standard error of 5 8- to 10-month-old animals/group) are expressed as percentage of lysis in graded salt concentrations. C50 values were determined by logarithmic linearization of the OF curve.26
Osmotic fragility test of wild-type and β-adducin −/− mice
| . | C50 ± SD [% (wt/vol) NaCl] . |
|---|---|
| +/+ Young | 0.517 ± 0.016 |
| +/− Young | 0.510 ± 0.010 |
| −/− Young | 0.569 ± 0.015 |
| +/+ Old | 0.501 ± 0.014 |
| +/− Old | 0.545 ± 0.011 |
| −/− Old | 0.585 ± 0.025 |
| . | C50 ± SD [% (wt/vol) NaCl] . |
|---|---|
| +/+ Young | 0.517 ± 0.016 |
| +/− Young | 0.510 ± 0.010 |
| −/− Young | 0.569 ± 0.015 |
| +/+ Old | 0.501 ± 0.014 |
| +/− Old | 0.545 ± 0.011 |
| −/− Old | 0.585 ± 0.025 |
Five animals of each group were analyzed, and the reported values correspond to the mean values. The experiment was repeated 2 times with similar results. +/+ and −/− indicate normal littermate controls and β-adducin mutant animals, respectively. Young and Old indicate 2- to 4-month-old and 8- to 9-month-old animals, respectively.
These results indicate a marked increase in the OF of RBCs in the β-adducin −/− mice that together with mild elliptocytosis defines in humans a disorder called spherocytic hereditary elliptocytosis (SphHE).29
Protein analysis of RBC ghosts and skeletons of β-adducin −/− mice
To quantitate the relative amounts of skeletal proteins, RBC ghosts and skeletal proteins from normal and mutant mice were run in SDS-PAGE Laemmli gels. Coomassie stained gels were scanned and analyzed by densitometry, and the protein concentration was normalized by subtracting hemoglobin (Hb) from the total amount of proteins and on the basis of band 3 content. This correction was done to eliminate errors in protein loading and those introduced by the different Hb concentrations between wild-type and mutant mice. We observed normal levels of α- and β-spectrin, ankyrin, band 3, protein 4.2, and protein 4.1 in β-adducin −/−RBCs ghosts and skeletons (Figure6A). However, there was a 15% reduction in actin levels (± 5%, n = 3) and a threefold increase in Hb retention in −/− RBCs skeleton. An unidentified 65 kd protein in the region corresponding to band 4.5 was missing both in ghosts and skeletons of β-adducin −/− mice. Also, the levels of various unknown proteins were slightly increased in the region of 25-40 kd. Finally, the relative amount of an 18 kd protein was increased in the −/− skeletal preparation.
Analysis of ghost and skeletal proteins in β-adducin mutant mice.
(A) Coomassie blue stained gels (SDS-PAGE) of ghosts and membrane skeletons (30 μg and 35 μg for ghost and skeleton, respectively) from normal (+/+) and mutant (−/−) mice. The major proteins are indicated. Variations between normal and mutant animals are indicated by arrows. (B and C) Western blot analysis of ghost proteins (3 μg and 8 μg, respectively) of adult wild-type (+/+), heterozygous (+/−), and homozygous mutant (−/−) mice using a rabbit anti-rat α-adducin polyclonal antibody (panel B) or a rabbit anti-mouse-γ-adducin antibody (panel C).
Analysis of ghost and skeletal proteins in β-adducin mutant mice.
(A) Coomassie blue stained gels (SDS-PAGE) of ghosts and membrane skeletons (30 μg and 35 μg for ghost and skeleton, respectively) from normal (+/+) and mutant (−/−) mice. The major proteins are indicated. Variations between normal and mutant animals are indicated by arrows. (B and C) Western blot analysis of ghost proteins (3 μg and 8 μg, respectively) of adult wild-type (+/+), heterozygous (+/−), and homozygous mutant (−/−) mice using a rabbit anti-rat α-adducin polyclonal antibody (panel B) or a rabbit anti-mouse-γ-adducin antibody (panel C).
Western blot analysis revealed the absence of β-subunit in −/− ghosts as was shown in Figure 2E. Surprisingly, when the same preparation of proteins was analyzed with an anti-α-adducin antibody, we detected a sharp decrease in the amount of this subunit in −/− mice but not in heterozygous animals. The levels of the α-subunit in mutant animals were reduced to about 20% of that of the wild-type mice (Figure 6B). When we used an anti-mouse γ-adducin antibody, we detected this subunit in RBCs from wild-type mice, contrary to that observed in humans. Furthermore, we observed a fourfold up-regulation of the γ-adducin levels both in +/− and −/− mice (Figure 6C).
These data suggest that α-adducin is not able to form stable homodimers or homotetramers capable of rescuing the absence of the β-subunit, and, as a consequence, it is not stably incorporated into the RBC membrane skeleton. Some of the adducin found in mouse erythrocytes may be composed of α/γ and/or β/γ heteromers, although we cannot rule out the presence of homomers. The increase in the γ-subunit may partially rescue the total absence of the β-adducin in −/− animals.
Our results indicate that the absence of β-adducin and consequent altered levels of the α- and γ-adducin subunits in the erythrocyte affect the normal structure of the membrane skeleton, producing a marked increase in OF, altered hematological parameters, and erythrocyte dysmorphology. The β-adducin-deficient mice develop a mild hemolytic anemia, in many ways similar to human SphHE.
Discussion
The in vivo role of β-adducin in erythrocytes was addressed by creating a mouse model bearing a large deletion that eliminates most of the known functional domains from the mature protein. Although a shorter mRNA form was clearly visible in spleen Northern blots, β-adducin-related sequences could not be detected by Western blot both in RBC ghosts and cytoplasm. The nonfunctional translated product, if present, was probably degraded. In humans, erythrocyte adducin is found exclusively associated to the red cell skeleton as a mixture of α and β heteromers in a tightly controlled stoichiometry (1:1 ratio of α/β adducin subunits9). However, in reticulocytes, the α-adducin mRNA is present in at least 20-fold higher levels than the β-adducin mRNA.2 Thus, the β-adducin subunit is rate limiting for the assembly of the α/β-adducin oligomeric molecule. Contrary to the previous findings,2 3 we detected γ-adducin in RBCs of normal mice, suggesting that also some proportions of α/γ and/or β/γ oligomers might be present. We observed a fourfold increase in γ-adducin levels in mutant mice, although this observation was not enough to completely rescue the absence of the β-subunit. The lack of the β-subunit produced an 80% decrease of α-adducin levels in mature erythrocytes, suggesting that, whenever it is not stably incorporated into the membrane skeleton as part of the adducin molecule, the α-subunit is degraded. This finding also indicates that the α/γ oligomers are a minor species in normal RBCs. Considering that we still detect approximately 20% of the amount of α-adducin normally found in wild-type animals and that the γ-subunit levels are fourfold increased in the mutant mice, we can hypothesize that the amount of α/γ heteromers in normal red mouse cells might not be higher than 5% of the total adducin. We infer that the observed changes in erythrocyte phenotype reflect the complete absence of β-adducin and the presence of only 20% of the α-subunit in the mutant mice. The up-regulation of the γ-subunit (by mean of αγ heteromers) may compensate for the absence of the β-subunit and might account for the mild phenotype. However, although our antibodies do not detect deleted β-adducin isoforms generated by translation of an abnormally spliced mRNA, we cannot completely rule out their existence and their potential effect on the phenotype.
We found that the β-adducin mutant mice suffer from a mild hemolytic anemia characterized by a marked increase in the OF of RBCs, a significant decrease in mean corpuscular volume (MCV) and hematocrit, an increase in MCHC and reticulocyte counts, along with abnormalities in the shape of the red cells. These data indicate the presence of dehydrated RBCs and the loss of membrane surface responsible for the observed increase in OF.
SphHE is a phenotypical hybrid of mild hereditary elliptocytosis (HE) and hereditary spherocytosis (HS), and its molecular basis is poorly understood.28,29 For example, in some patients with SphHE, mutations in β-spectrin30 and protein 4.1 deficiency31,32 were detected. In SphHE, red cells are osmotically fragile in the range found in HS. Elliptocytes are less pronounced and somewhat rounded, but no poikilocytes or fragmented forms are present.33 The peripheral blood smear of our mutant mice showed the presence of mild elliptocytosis with subtle morphological changes, a feature already observed in human spherocytic HE.34 Also, as already observed in human SphHE, only a few spherocytes are present, although an increased OF in erythrocytes characteristic of this phenotype was clearly detected. However, the morphological changes in the mouse RBCs are overall less marked than those observed in human spherocytic HE.
Because adducin participates in the early events of skeletal connections formation,2 it is possible that the increased OF, altered hematological parameters, and the observed elliptocytosis in RBCs are produced by the assembly of an anomalous skeleton due to the absence of β-adducin in the mutant mice. One of the adducin functions in RBCs is recruiting additional spectrin molecules to the spectrin-actin junctional complexes.16 Furthermore, the defect of adducin as an actin barbed-end capping protein18may affect actin filament length. Indeed, actin content in RBC mutant skeletons was slightly but significantly reduced (15% less than wild type). Consequently, the absence of β-adducin in the mutant erythrocytes may produce defective junctional complexes.
In parallel to the submission of our manuscript, Gilligan et al.35 submitted and then published similar data to that presented here. However, minor differences between both models were observed. Regarding the RBC morphology description and interpretation, we see predominance of elliptocytes, whereas their predominant feature is spherocytosis.35 Erythrocytes from both animal models were osmotically fragile and had smaller MCV. Also, all the other hematological parameters were similar. It is important to note that our mouse mutants were backcrossed for 5 generations, being at least 98% identical to the C57Bl/6 genetic background, whereas Gilligan et al.35 studied the β-adducin mutation phenotype within a mixed 50% SvC129 and 50% C57Bl/6 genetic background. It has been previously reported for other gene knockout mice that the phenotype may vary with different genetic backgrounds.36-38 This observation could be the cause of the differences seen between our mutant animals and those of Gilligan et al. We have not observed the presence of a deleted β-adducin isoform either in ghosts or in erythrocyte cytoplasm of mutant mice. However, a deleted isoform containing a portion of the antisense strand of the NeoR gene was found by Gilligan et al.35 Our targeting construct differs from theirs in the orientation of the NeoR and the absence of any deleted isoform may derive from this fact. We have used 2 sets of polyclonal antibodies, 1 set raised against the full-length β-adducin (β-Add97 or β-1 adducin) and the other set raised against the translation product of the deleted mRNA found in spleen (Δ9-13 β-adducin; Figures 1 and 3). However, we cannot rule out a marked epitope preference in both sets of antibodies that hinder the detection of deleted forms.
The association between adducin variants or adducin deficiency with RBC membrane disorders has not previously been firmly established. The β-adducin knockout mouse models have demonstrated the importance of adducin in the maintenance of RBC shape and membrane stability. Our work shows the RBC abnormalities derive from the absence of β-adducin in the erythrocyte membrane skeleton and its consequences such as the 80% decrease and fourfold up-regulation of the α- and γ-adducins, respectively. The observed phenotype is reminiscent of the human disorder called SphHE.
Acknowledgments
We wish to thank J. Flo for critical discussion of the experiments and statistical analysis; G. Devescovi for help with cDNA cloning and Northern blot analysis; G.C. Lunazzi and M. Sturnega for animal care; G. Dal Negro and his group, Glaxo Wellcome, Verona, for the assistance with the Technicon H-1 cell analyzer and reticulocyte count; Reiber Electronics and Leo and M. Tudja and Pliva for using the electron microscope; D. Lohnes for the pD350.1 plasmid; P. Gruss and A. Voss for the MPI II ES cells; G. Stanta and I. Kardum-Skelin for technical help in histology and cytology; R. Kemler for the NeoR mice; and M. Lemeur and P. Chambon for help in the initial stages of KO production.
Supported by ICGEB grant CRP/CRO 96-01 (S. Gajović).
Reprints:Francisco E. Baralle, ICGEB, Padriciano 99, I-34012, Trieste, Italy; e-mail: baralle@icgeb.trieste.it.
The publication costs of this article were defrayed in part by page charge payment. Therefore, and solely to indicate this fact, this article is hereby marked “advertisement” in accordance with 18 U.S.C. section 1734.

This feature is available to Subscribers Only
Sign In or Create an Account Close Modal